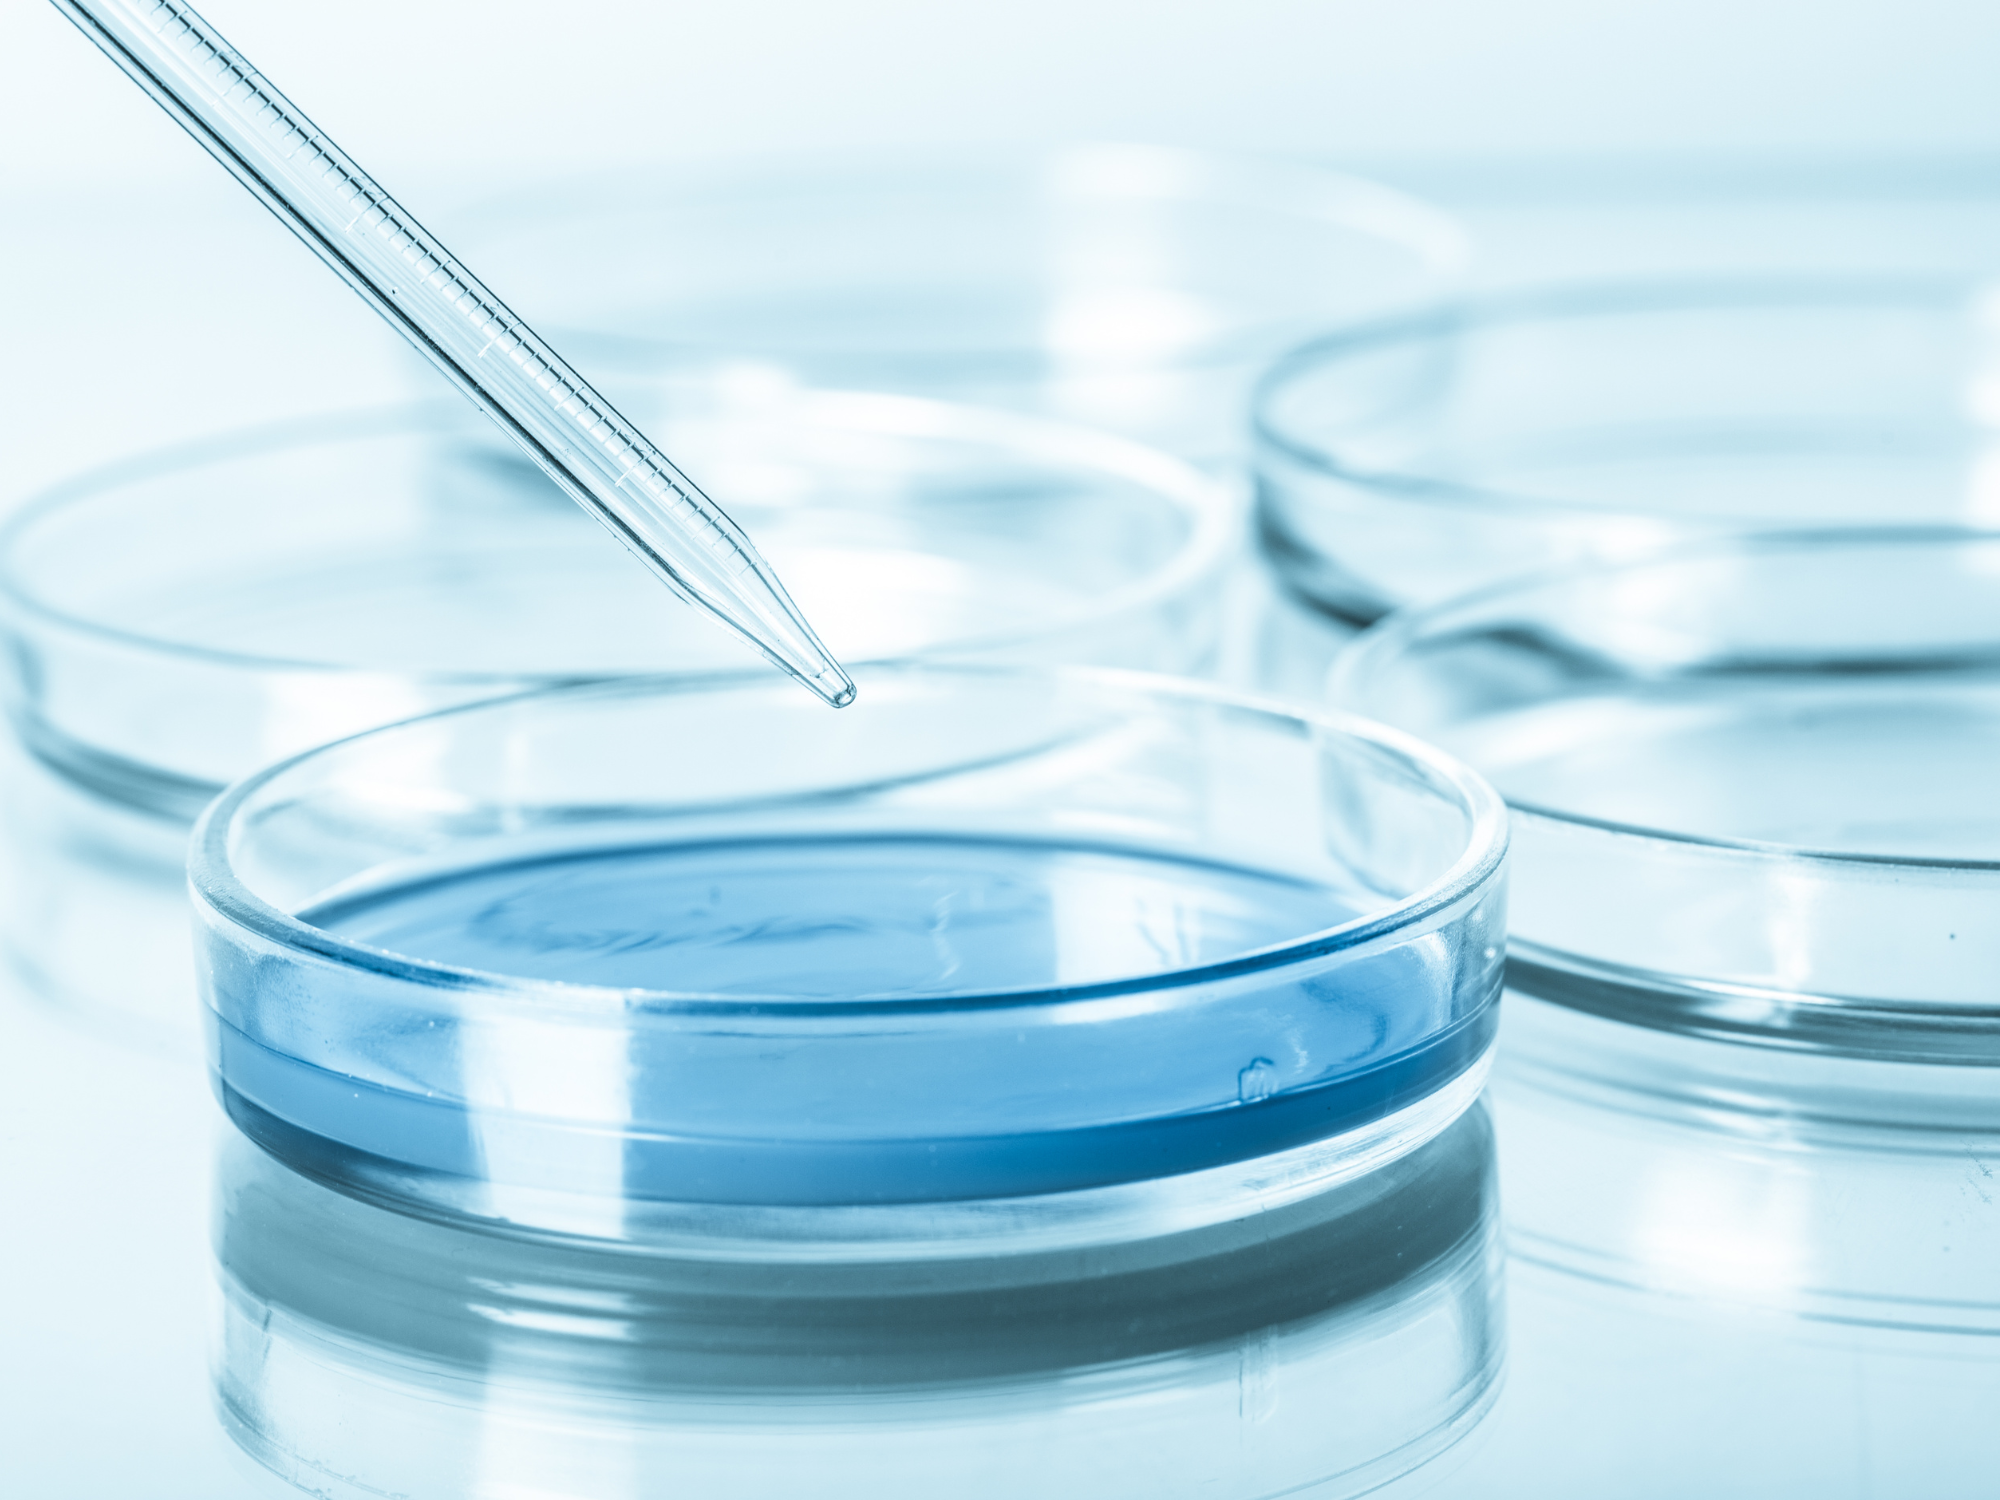
BTS Biologie Médicale Paris : quelle école choisir et pourquoi Linova Formation fait la différence ?

Débouchés Alternance Initial BTS Biologie Médicale Actualité
Les qualités indispensables pour devenir technicien(ne) de laboratoire
En savoir plus
Débouchés Alternance Initial BTS Biologie Médicale Actualité
Stage en BTS Biologie Médicale : comment le réussir et en tirer le meilleur ?
En savoir plus
Débouchés Alternance Initial BTS Biologie Médicale Actualité
BTS Biologie Médicale ou Licence Sciences de la Vie : que choisir ?
En savoir plus
Alternance Initial BTS Biologie Médicale Actualité Débouchés
Comment s’inscrire à un BTS Biologie Médicale ?
En savoir plus
Initial BTS Biologie Médicale Actualité Débouchés Alternance
BTS Biologie Médicale : matières, cours et programme détaillé
En savoir plus
Initial BTS Biologie Médicale Actualité Débouchés Alternance
BTS Biologie Médicale Paris : quelle école choisir et pourquoi Linova Formation fait la différence ?
En savoir plus
BTS Biologie Médicale Actualité Débouchés Alternance Initial
Biologie médicale et intelligence artificielle : quels impacts sur les futurs techniciens de laboratoire ?
En savoir plus
BTS Biologie Médicale Actualité Débouchés Alternance Initial
Devenir technicien(ne) de laboratoire : portrait d’un métier en tension Introduction
En savoir plus
BTS Biologie Médicale Actualité Débouchés
Quel salaire après un BTS Biologie Médicale ?
En savoir plus
Débouchés BTS Biologie Médicale
Travailler dans la biologie médicale : quels métiers après un BTS ?
En savoir plus
